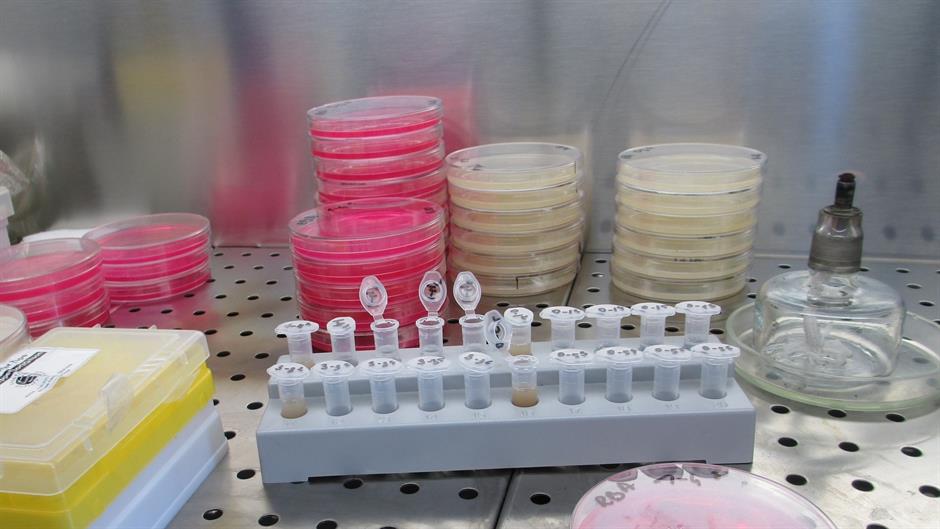
laboratory-829371_1920

Srčane bolesti više nisu vodeći uzrok smrti u bogatim zemljama, sada je to karcinom koji bi mogao postati najveći svjetski ubojica u samo nekoliko desetljeća ako se nastave sadašnji trendovi, upozorili su u utorak znanstvenici.
Oglas
Objavljujući otkrića dvije velike studije u medicinskom časopisu The Lancet, znanstvenici su izjavili da su iznijeli dokaze nove globalne "epidemiološke tranzicije" između različitih vrsta kroničnih bolesti.
Dok kardiovaskularne bolesti ostaju, zasad, vodeći uzrok mortaliteta diljem svijeta među ljudima u srednjim godinama - i na njih otpada 40 posto svih smrti - to više nije slučaj u zemljama s visokih prihodima gdje rak sada ubija dvostruko više ljudi od srčanih bolesti, pokazali su rezultati studija.
"Naše rad je otkrio da je rak bio drugi najčešći uzrok smrti u svijetu 2017. i da je na njega otpalo 26 posto svih smrti. No dok stopa (srčanih bolesti) nastavlja padati, karcinom bi mogao postati vodeći uzrok smrti diljem svijeta u samo nekoliko desetljeća", rekao je Gilles Dagenais, profesor sa Sveučilišta Laval u Quebecu u Kanadi, koji je bio jedan od voditelja tog rada.
Od oko 55 milijuna smrti u svijetu 2017. godine, rekli su znanstvenici, oko 17,7 milijuna umrlo je od kardiovaskularnih bolesti.
U pozadini otprilike 70 posto tih bolesti su visoki krvni tlak, visoki kolesterol, loša prehrana i pušenje - čimbenici na koje se može utjecati.
U zemljama s visokim dohotkom liječenje visokog kolesterola i tlaka lijekovima pomoglo je u smanjenju stopa oboljelih od srčanih bolesti u zadnjih nekoliko desetljeća.
Dagenaisov tim rekao je da njihova otkrića sugeriraju da bi uzrok veće stope smrti od srčanih bolesti u siromašnijim zemljama mogla biti slabija kvaliteta zdravstvene skrbi.
Istraživanje je pokazalo da su stope prve hospitalizacije i korištenja lijekova za srčane bolesti puno niže u siromašnijim zemljama i onim sa srednjim dohotkom nego u bogatim državama.
Ovo istraživanje dio je urbane i ruralne epidemiološke (PURE) studije, objavljene u Lancetu i predstavljene na ESC kongresu u Parizu.
Među analiziranim zemljama bili su Argentina, Bangladeš, Brazil, Čile, Filipini, Indija, Iran, JAR, Kanada, Kina, Kolumbija, Malezija, Pakistan, Poljska, Saudijska Arabija, Švedska, Tanzanija, Turska, Ujedinjeni Arapski Emirati i Zimbabve.
N1 pratite putem aplikacija za Android |iPhone/iPad | Windows| i društvenih mreža Twitter| Facebook | Instagram.
Kakvo je tvoje mišljenje o ovome?
Pridruži se raspravi ili pročitaj komentare
Oglas
Kakvo je tvoje mišljenje o ovome?
Pridruži se raspravi ili pročitaj komentare
Oglas
NAJČITANIJE
Oglas
Oglas
Najnovije
Oglas
Oglas